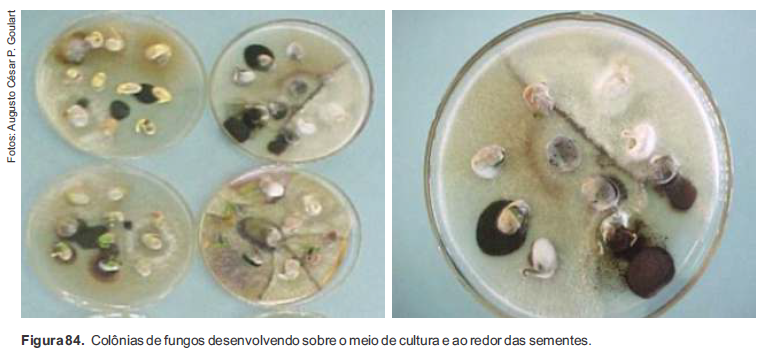
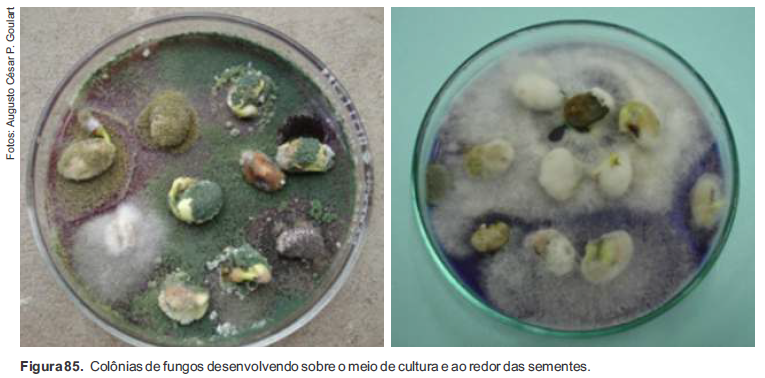
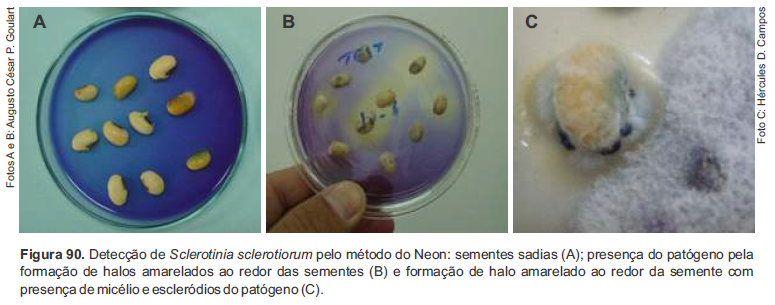
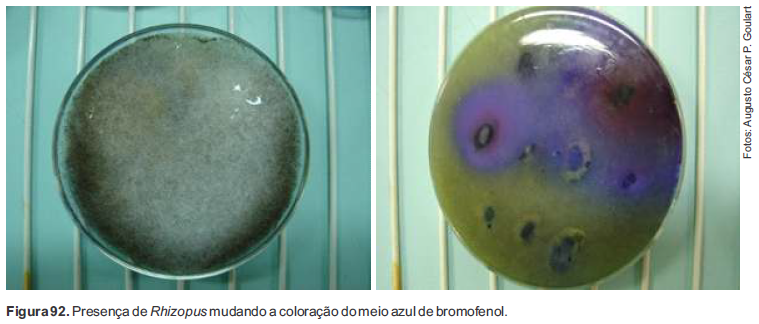
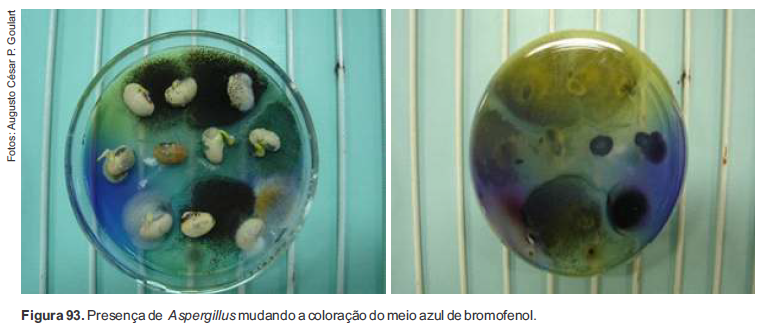

Métodos de Detecção de Patógenos em Sementes de Soja
Existem vários testes de laboratório que podem ser utilizados para caracterizar o estado sanitário das sementes de soja, sendo que a seleção de um método em particular dependerá do patógeno a ser detectado, da espécie de semente e do próprio objetivo do teste.
O principal método utilizado na análise sanitária de sementes de soja é o do papel de filtro (blotter test). É considerado o método padrão para a detecção de fungos em sementes de soja e internacionalmente recomendado pela International Seed Testing Association (ISTA).
A experiência tem comprovado que este método é perfeitamente viável e o mais eficaz para a cultura. Em casos específicos, o método pode ser alterado, variando-se a temperatura e o período de incubação para detectar patógenos como Sclerotinia sclerotiorum, por exemplo. A seguir, esses métodos serão descritos, detalhadamente.
Incubação em substrato de papel ou método do papel de filtro (blotter test)
a) Número de sementes para análise: 200 a 400 sementes.
b) Procedimentos – Este método consiste na utilização de sementes, sem assepsia superficial, semeadas em placas de Petri ou caixas Gerbox, contendo três folhas de papel de filtro previamente esterilizadas, embebidas numa solução de 2,4-D (2,4 - dicloro- fenóxiacetato de sódio), a 0,01% do produto comercial (1.000 ml de água destilada esterilizada + 1 ml do herbicida 2,4-D) e em ágar diluído (10 g de ágar/1.000 ml de água) para facilitar a fixação das sementes no substrato. As sementes são dispostas em número de 20, por recipiente (Figura 82).

c) Condições de incubação – Os recipientes contendo as sementes são incubados por um período de 7 dias, em ambiente controlado, com temperatura entre 20 °C–22 °C, sob regime de 12 horas de luz (negra “NUV” e/ou branca fluorescente tipo “luz do dia”)/12 horas de escuro. O objetivo da utilização da luz é o de estimular a esporulação da maioria dos fungos.
d) Avaliação/exame das sementes – Após o período de incubação, as sementes são examinadas, uma a uma, sob microscópio estereoscópico com resolução de 30X–80X e os microrganismos são identificados e anotados. A identificação é feita com base na esporulação dos fungos (frutificações típicas do crescimento dos fungos). Ressalta-se que conidióforos com conídios e corpos de frutificação (e.g., picnídios, acérvulos, peritécios) formados nas sementes são características importantes para identificar espécies fúngicas. Observações de lâminas ao microscópio ótico são, algumas vezes, necessárias para confirmar a identidade dos fungos em nível de espécie. Os resultados devem ser expressos em percentual de ocorrência dos fungos.
e) Observação – A utilização do 2,4-D tem por finalidade inibir a germinação das sementes, a fim de facilitar a leitura do teste. Este tratamento leva à morte do embrião, sem causar efeito negativo na flora fitopatogênica. Para sementes tratadas com fungicidas, o período de incubação deve ser prolongado por mais 3 dias.

Incubação em substrato de papel ou método do papel de filtro (blotter test) com congelamento (deep freezing method)
a) Número de sementes para análise: 200 a 400 sementes.
b) Procedimentos – Este método consiste em pequena variação do anterior, no qual elimina-se a germinação, não pelo uso do 2,4-D mas pela exposição das sementes à temperatura de -20 °C. As sementes de soja são semeadas em caixas Gerbox contendo três folhas de papel de filtro previamente esterilizadas e embebidas em ágar diluído (10 g de ágar/1.000 ml de água) para facilitar a fixação das sementes no substrato. As sementes são dispostas em número de 20, por recipiente (Figura 83). Os resultados devem ser expressos em percentual de ocorrência dos fungos.

c) Condições de incubação – As sementes são incubadas, sob as mesmas condições já descritas no teste anterior, nas primeiras 24 horas. Após esse período, os recipientes são retirados e colocados em um freezer a -20°C, por 24 horas. Posteriormente, voltam ao ambiente normal de incubação por 5 dias, perfazendo assim os 7 dias, quando então é realizada a avaliação.
d) Avaliação/exame das sementes – Realizado conforme já descrito no teste anterior.
e) Observação – O choque de frio, após as sementes absorverem água nas primeiras 24 horas de incubação, prejudica a germinação normal. Os microrganismos desenvolvem-se normalmente durante a incubação e a avaliação fica facilitada, uma vez que não ocorre a germinação das sementes.
Método de incubação em BDA – plaqueamento em meio ágar sólido
a) Número de sementes para análise: 200 a 400 sementes.
b) Procedimentos – Neste tipo de teste, inicialmente as sementes necessitam sofrer assepsia superficial com solução de hipoclorito de sódio a 1,5% (água sanitária); 2:1 v/v (duas partes de água e uma parte do produto comercial). Para isso, submergem-se as sementes na solução por 5 minutos. Esse processo tem por finalidade eliminar microrganismos presentes na superfície das sementes, sem afetar os patógenos localizados internamente. As sementes, após secagem rápida em papel de filtro esterilizado, são distribuídas em placas de Petri (10 sementes/placa – Figuras 84 e 85), de 9 cm de diâmetro, contendo 10 ml do meio BDA (extrato de 200 g de batata; 20 g de dextrose; 12 g a 20 g de ágar e água destilada para completar 1.000 ml). A esse meio, antes da autoclavagem, adiciona-se 2,4-D a 0,01%.

c) Condições de incubação – As placas com as sementes são incubadas em ambiente controlado, sob as mesmas condições descritas no item “Incubação em substrato de papel ou método do papel de filtro (blotter test)”, por um período de 7 dias.
d) Avaliação/exame das sementes – Após o período de incubação, a avaliação é realizada a olho nu, baseando-se nas características das colônias que se desenvolvem sobre o meio de cultura e ao redor das sementes. Cor, textura, morfologia geral e a presença de corpos de frutificação podem auxiliar no reconhecimento das espécies fúngicas. Quando necessário, as sementes devem ser examinadas individualmente ao microscópio estereoscópico, para confirmação do diagnóstico.

Métodos específicos
Alguns fungos não são facilmente detectados nas sementes pelo método de incubação em substrato de papel (“blotter test”). Dessa forma, métodos específicos foram desenvolvidos com o objetivo de detectar com rapidez e maior precisão determinados patógenos.
A seguir, serão descritos três métodos específicos para a detecção de Sclerotinia sclerotiorum em sementes de soja.
Rolo de papel-toalha modificado
a) Número de sementes para análise: 200 a 400 sementes.
b) Procedimentos – As sementes, em número de 50 por rolo, são distribuídas uniformemente sobre duas folhas de papel de germinação (papel-toalha), tamanho 44 cm × 34 cm, umedecidas com água destilada, em seguida cobertas com uma terceira folha umedecida e daí procedendo-se ao enrolamento dos conjuntos. A desinfestação superficial das sementes é recomendada por meio de solução 1% de hipoclorito de sódio por 3 minutos.
c) Condições de incubação – Os rolos de papel são mantidos em câmara de incubação, por um período de 12 dias, na ausência de luz, com temperatura de 16 °C.
d) Avaliação/exame das sementes – Após o período de incubação, as sementes são examinadas, uma a uma, a olho nu, sendo que a identificação é feita com base na presença de micélio tipicamente branco de S. sclerotiorum com formação de escleródios negros, de forma esférica, irregulares e tamanho de 2 mm a 10 mm, ao redor das sementes infectadas (Figuras 86 e 87).


Blotter test modificado
a) Número de sementes para análise: 200 a 400 sementes.
b) Procedimentos – Este método consiste na distribuição de sementes em caixas Gerbox, contendo três folhas de papel de filtro previamente esterilizadas, embebidas numa solução de 2,4-D (2,4 – diclorofenóxiacetato de sódio), a 0,01% do produto comercial (1.000 ml de água destilada esterilizada + 1 ml do herbicida 2,4-D) e em ágar diluído (10 g de ágar/1.000 ml de água) para facilitar a fixação das sementes no substrato. As sementes são dispostas em número de 20, por recipiente. A desinfestação superficial das sementes é recomendada por meio de solução 1% de hipoclorito de sódio por 3 minutos. Os resultados devem ser expressos em percentual de ocorrência dos fungos.
c) Condições de incubação – Em seguida, os recipientes contendo as sementes são incubados por um período de 14 dias, na ausência de luz, com temperatura de 18 °C.
d) Avaliação/exame das sementes – Após o período de incubação, as sementes são examinadas, uma a uma, a olho nu, sendo que a identificação é feita com base na presença de micélio tipicamente branco de S. sclerotiorum com formação de escleródios negros, de forma esférica, irregulares e tamanho de 2 mm a 10 mm, ao redor das sementes infectadas (Figuras 88 e 89).


Incubação em meio ágar – bromofenol (Neon)
a) Número de sementes para análise: 200 a 400 sementes.
b) Procedimentos – As sementes são colocadas em meio BDA, contendo 150 mg/L de azul de bromofenol, 150 mg/L de sulfato de estreptomicina e 150 mg/L de penicilina G. Como alternativa ao uso dos antibióticos sulfato de estreptomicina e penicilina G pode se usar 50 g de cloranfenicol. O pH final deve ser ajustado para 4,7 com HCl ou NaOH. O azul de bromofenol e os antibióticos são incorporados ao BDA fundido (50 °C) após autoclavagem. Distribuir 18 mL do meio por placa de Petri de 9 cm de diâmetro.

c) Condições de incubação – Os recipientes contendo as sementes são incubados por um período de 7 dias, em ambiente controlado, com temperatura entre 20 °C–22 °C, sob regime de 12 horas de luz (negra “NUV” e/ou branca fluorescente tipo “luz do dia”)/12 horas de escuro.
d) Avaliação/exame das sementes – A partir do terceiro dia de incubação, observações devem ser realizadas para verificar a formação de halos amarelos ao redor das sementes (Figuras 90 e 91). O ácido oxálico produzido pelo fungo altera a cor do meio de cultura de azul para amarela. Para a confirmação da presença de S. sclerotiorum, observar as placas sobre uma base de vidro transparente com luz branca na base; a visualização de micélio superficial sobre o meio na zona do halo amarelado, partindo das sementes, confirma a presença do fungo em foco.

e) Este método é específico para detecção de S. sclerotiorum, porém algumas espécies de Rhizopus (Figura 92), Aspergillus (Figura 93) e Sclerotium também podem também provocar alteração da cor do meio. Nesses casos, a formação de frutificações típicas dessas espécies pode ser facilmente distinguida de Sclerotinia.

Se você tem interesse em saber mais sobre a Cultura da Soja, te convido a conhecer a plataforma da AgricOnline. Ao fazer a sua assinatura, você tem acesso ilimitado a todos os cursos da plataforma. São cursos que vão desde produção vegetal, produção animal, mercado e carreira.
Ao término de cada curso, você tem direito ao certificado com a carga horária de cada curso, clique no link para conhecer.

Ou clique no link:
https://go.agriconline.com.br/pass/?sck=portal
Fonte
GOULART, Augusto César Pereira. Fungos em Sementes de Soja Detecção, Importância e Controle. 2ª ed. Brasília – DF: Embrapa, 2018.